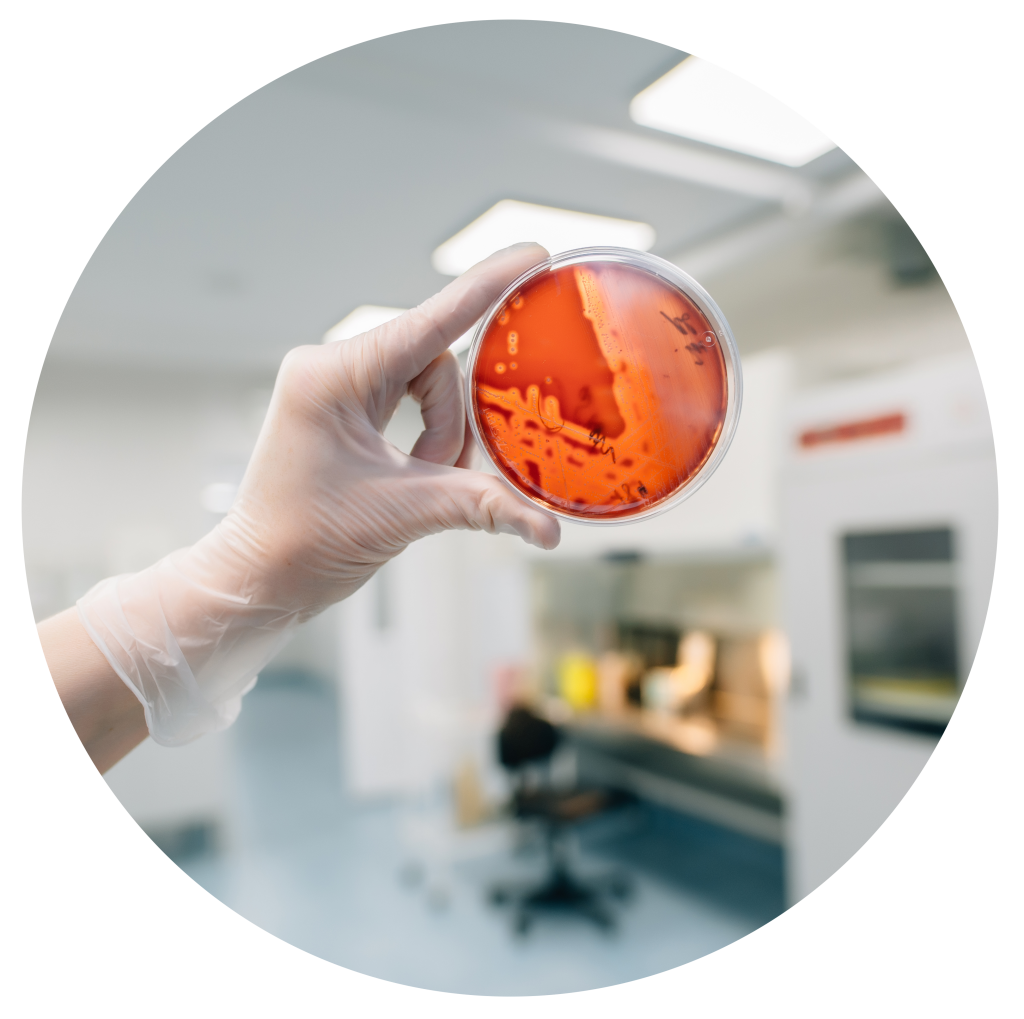
Аллергология 2 (астма).png

Аллергология-иммунология
О направлении
Врачи аллергологи-иммунологи Северо-Западного Центра доказательной медицины занимается диагностикой и лечением аллергических реакций организма у взрослых.
Когда необходимо обратиться к врачу аллергологу-иммунологу?
Аллергия – это форма иммунного ответа, специфическая повышенная чувствительность организма к аллергену. Реакция иммунной системы на повторный контакт с аллергеном приводит к повреждению тканей биологически активными веществами, высвобождающимися в избыточном количестве.
Каждый организм реагирует на те или иные аллергены по-разному. Именно из-за этого возрастает риск развития аллергических реакций:
-
отёк Квинке
-
бронхиальная астма
-
сывороточная болезнь
-
аллергическая крапивница
-
аллергический конъюнктивит
-
анафилактический шок
-
контактный аллергический дерматит
-
аллергический круглогодичный ринит
-
поллиноз (аллергический сезонный ринит)
-
поллиноз (сезонный риноконъюнктивит)
-
экзогенный аллергический альвеолит
-
атопический дерматит
Как проходит прием у врача аллерголога-иммунолога?
Врач аллерголог-иммунолог АО "СЗЦДМ" подробнейшим образом опрашивает и осматривает пациента, обращает внимание на такие подробности, о которых мог не задумываться обратившийся человек. Доктор выясняет, имели ли место подобные недомогания ранее в тот же сезонный период, есть ли перекрестная пищевая аллергия, есть ли связь клинических проявлений с предполагаемыми аллергенами, страдали ли аллергией близкие родственники, насколько напряженным сейчас является распорядок жизни у пациента. Эти вопросы позволяют составить полное и точное мнение о возможных причинах, спровоцировавших развитие аллергической реакции в данный момент. Какими бы очевидными ни казались причины заболевания, специалист обязан назначить ряд специфических анализов – только по их результатам может быть назначен полноценный курс лечения.
С каждым годом количество людей, у которых возникают те или иные аллергические реакции, многократно возрастает.
Наиболее часто встречающиеся аллергические реакции
- Аллергический конъюнктивит. Заболевание, характеризующееся аллергическим воспалением конъюнктивы глаз, вызванное этиологически значимым аллергеном.
- Сезонный аллергический конъюнктивит. Развивается при сенсибилизации к пыльцевым (пыльца деревьев, злаковых, сорных трав и др.) и грибковым (споры грибов Cladosporium, Penicillium, Alternaria и др.) аллергенам. Характеризуется сезонностью клинических проявлений, совпадающей с периодом пыления причинно-значимых аллергенов или воздействием аллергенов (при микогенной аллергии) на людей определенных профессий.
- Круглогодичный аллергический конъюнктивит. Развивается при сенсибилизации к аллергенам домашней пыли, клещам домашней пыли, библиотечной пыли, шерсти, перхоти, слюне животных, пуху и перу птиц, плесневым грибам, профессиональным и другим аллергенам. Характеризуется отсутствием сезонности и круглогодичным течением.
- Аллергический ринит. Это заболевание, характеризующееся наличием иммунологически обусловленного (чаще всего IgE-зависимого) воспаления слизистой оболочки носа, вызванного причинно-значимым аллергеном, и клинически проявляющееся ежедневно в течение не менее часа двумя и более симптомами: обильной ринореей, затруднением носового дыхания, зудом в полости носа, повторяющимся чиханием и нередко аносмией. Типичные симптомы ринита: ринорея, чихание, затруднение носового дыхания и зуд часто сочетаются с глазными симптомами, особенно у пациентов с повышенной чувствительностью к пыльцевым аллергенам.
- Атопический дерматит. Это высыпания, наличие или отсутствие расчесов, свидетельствующих об интенсивности кожного зуда, признаки инфицирования кожи, возможно сочетание с симптомами аллергического ринита, конъюнктивита, бронхиальной астмы. Процесс на коже часто носит характер хронического воспаления – эритема, папулы, шелушение, утолщение кожи (инфильтрация), усиление кожного рисунка (лихенизация), множественные экскориации (расчесы), трещины. На местах разрешения высыпаний участки гипо- или гиперпигментации. У некоторых детей формируется дополнительная складка нижнего века (симптом Денни-Моргана).
- Крапивница. Это группа заболеваний, характеризующаяся развитием волдырей и/или ангиоотеков. Волдырь при крапивнице имеет три характерных признака: центральный отек разных размеров, почти всегда окруженный рефлекторной эритемой; зуд, иногда ощущение жжения; обратимость, волдырь исчезает бесследно в течение 1–24 ч.
- Ангиоотек характеризуется следующими признаками: быстроразвивающийся отек глубоких слоев дермы, подкожной клетчатки и подслизистого слоя; чувство распирания и болезненности чаще, чем зуд; эритема может отсутствовать; разрешение в период до 72 ч.
Отдельно следует отметить такое заболевание, как бронхиальная астма.
Это гетерогенное заболевание, в основе которого лежит хроническое воспаление дыхательных путей. Астма – заболевание, протекающее с эпизодами затрудненного дыхания, одышки и кашля вследствие обратимой бронхиальной обструкции с высокочастотными свистящими хрипами, слышимыми во время дыхания, особенно на выдохе.
Симптомы – одышка, кашель, затруднение дыхания, стеснение в груди – изменяются с течением времени по характеру и интенсивности и зависят от ряда факторов:
- Наличие наследственной отягощенности по бронхиальной астме или другим аллергическим заболеваниям.
- Время суток: симптоматика астмы меняется в течение суток, обострение происходит преимущественно ночью и утром при пробуждении.
- Активность: состояние может ухудшаться после физической нагрузки.
- Воздействие других триггеров: контакт с домашними животными, холодная или влажная погода, эмоции или смех.
- Наличие в анамнезе повторных эпизодов бронхиальной обструкции, особенно протекающих на фоне нормальной температуры, вне эпизодов ОРВИ.
- Наличие других аллергических заболеваний.
В период обострения бронхиальной астмы определяется навязчивый сухой или малопродуктивный кашель (иногда до рвоты), экспираторная одышка, диффузные сухие свистящие хрипы в грудной клетке на фоне неравномерного ослабленного дыхания, вздутие грудной клетки, коробочный оттенок перкуторного звука. Шумное свистящее дыхание слышно на расстоянии. Кашель – рецидивирующий или стойкий непродуктивный кашель, который может обостряться в ночное время или сопровождаться свистящими хрипами или затруднением дыхания.
Кашель возникает при физической нагрузке, смехе, плаче или воздействии табачного дыма в отсутствие явной респираторной инфекции. Рецидивирующие свистящие хрипы возникают во сне или при воздействии таких провоцирующих факторов, как физическая активность, смех, плач, воздействие табачного дыма или загрязненного воздуха.
Полезная информация
Исследования воды